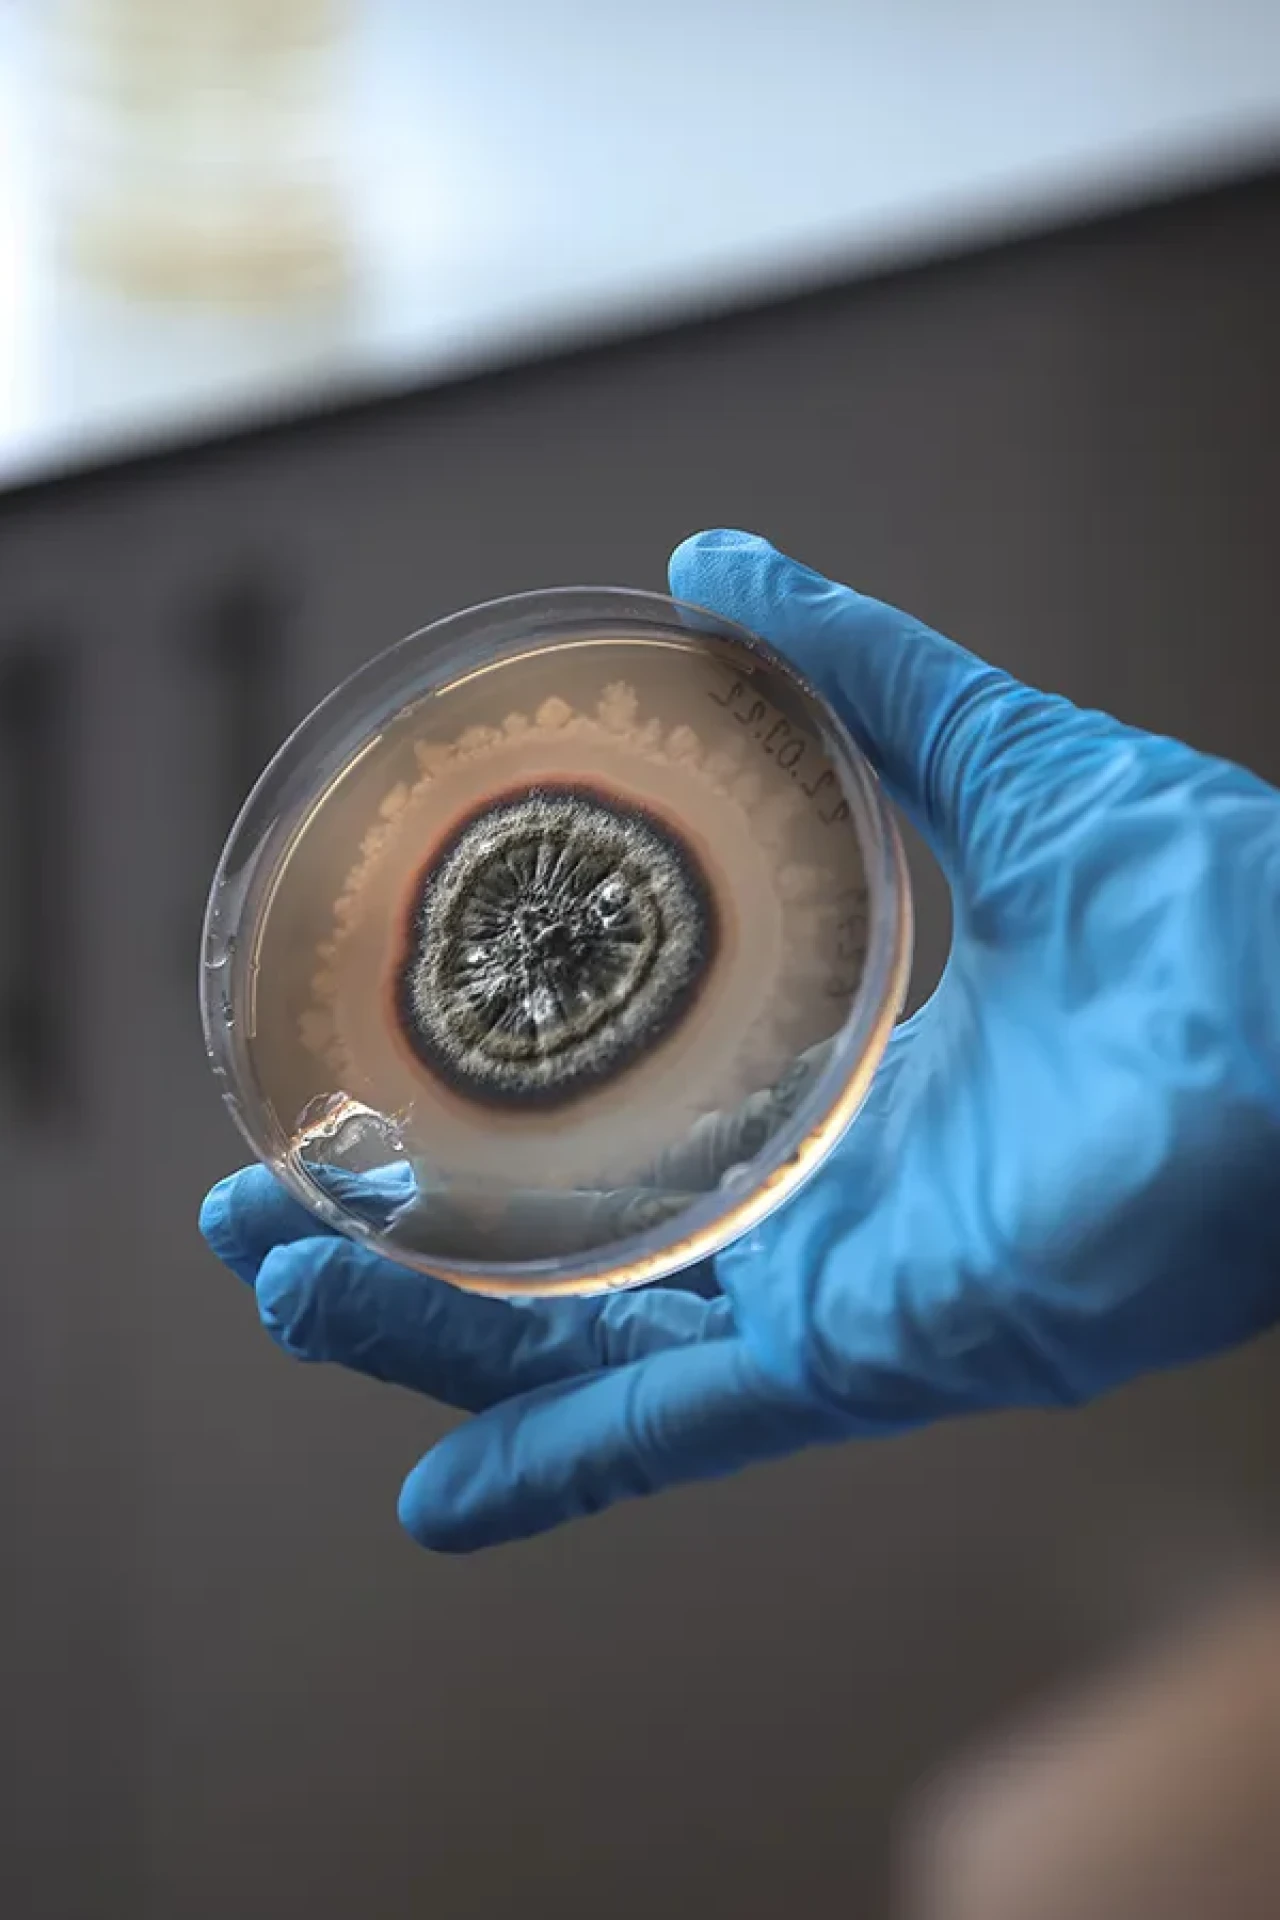
Pestisitlere dair her şey: Tarihçesi, Kullanım alanları ve sağlık etkileri neler?

Pestisit Nedir? Tarihçesi ve Günümüzdeki Kullanımı
Tarım ürünlerini böceklerden, yabancı otlardan ve hastalıklardan korumak için kullanılan kimyasal veya biyolojik maddelere pestisit denir. Kelimenin kökeni Latinceye dayanır: “pest” zararlı organizma, “sit” ise öldürmek anlamına gelir. Yani pestisit, kısaca “zararlı öldürücü” demektir.
Pestisitlerin Kısa Tarihçesi
Aslında pestisit kullanımı sanıldığı kadar yeni değil. Antik Mısır’da bile çiftçiler, bitkileri böceklerden korumak için kükürt kullanıyordu. Çin ve Yunan uygarlıkları da bitki özlerinden yararlanıyordu.
Modern anlamda pestisitlerin hikâyesi ise 20. yüzyılda başladı. 1939’da İsviçreli bilim insanı Paul Hermann Müller, ünlü DDT’yi keşfetti. Bu madde, II. Dünya Savaşı sırasında askerleri sıtma taşıyan sivrisineklerden korudu ve milyonlarca hayat kurtardı. Müller bu çalışmasıyla 1948’de Nobel Ödülü aldı.
 Ancak ilerleyen yıllarda DDT’nin doğaya ve insan sağlığına zararları ortaya çıktı. Kuşların yumurtalarını inceltmesi, sulara karışması ve insan vücudunda birikmesi gibi etkiler nedeniyle birçok ülkede yasaklandı.
Ancak ilerleyen yıllarda DDT’nin doğaya ve insan sağlığına zararları ortaya çıktı. Kuşların yumurtalarını inceltmesi, sulara karışması ve insan vücudunda birikmesi gibi etkiler nedeniyle birçok ülkede yasaklandı.
1962’de biyolog Rachel Carson’un “Sessiz Bahar” kitabı, pestisitlerin doğaya zararlarını gündeme taşıdı ve çevre bilincini artıran dönüm noktalarından biri oldu.
Günümüzde Pestisit Kullanımı
Bugün pestisitler farklı amaçlara göre sınıflandırılıyor:
İnsektisit: Böcek öldürücüler
Herbisit: Yabancı ot ilacı
Fungisit: Mantar öldürücüler
Rodentisit: Kemirgenlere karşı kullanılan ilaçlar
Doğru ve kontrollü kullanıldığında tarımsal verimi artıran pestisitler, bilinçsiz kullanımda hem toprağa hem suya hem de insan sağlığına zarar verebiliyor. Bu nedenle son yıllarda organik tarım ve biyolojik mücadele yöntemleri ön plana çıkmaya başladı.
Pestisitler, tarım için büyük bir kolaylık sağlasa da tek çözüm değil. Geleceğin tarımında daha dengeli, çevre dostu ve sürdürülebilir yöntemlerin önem kazanacağı kesin görünüyor.